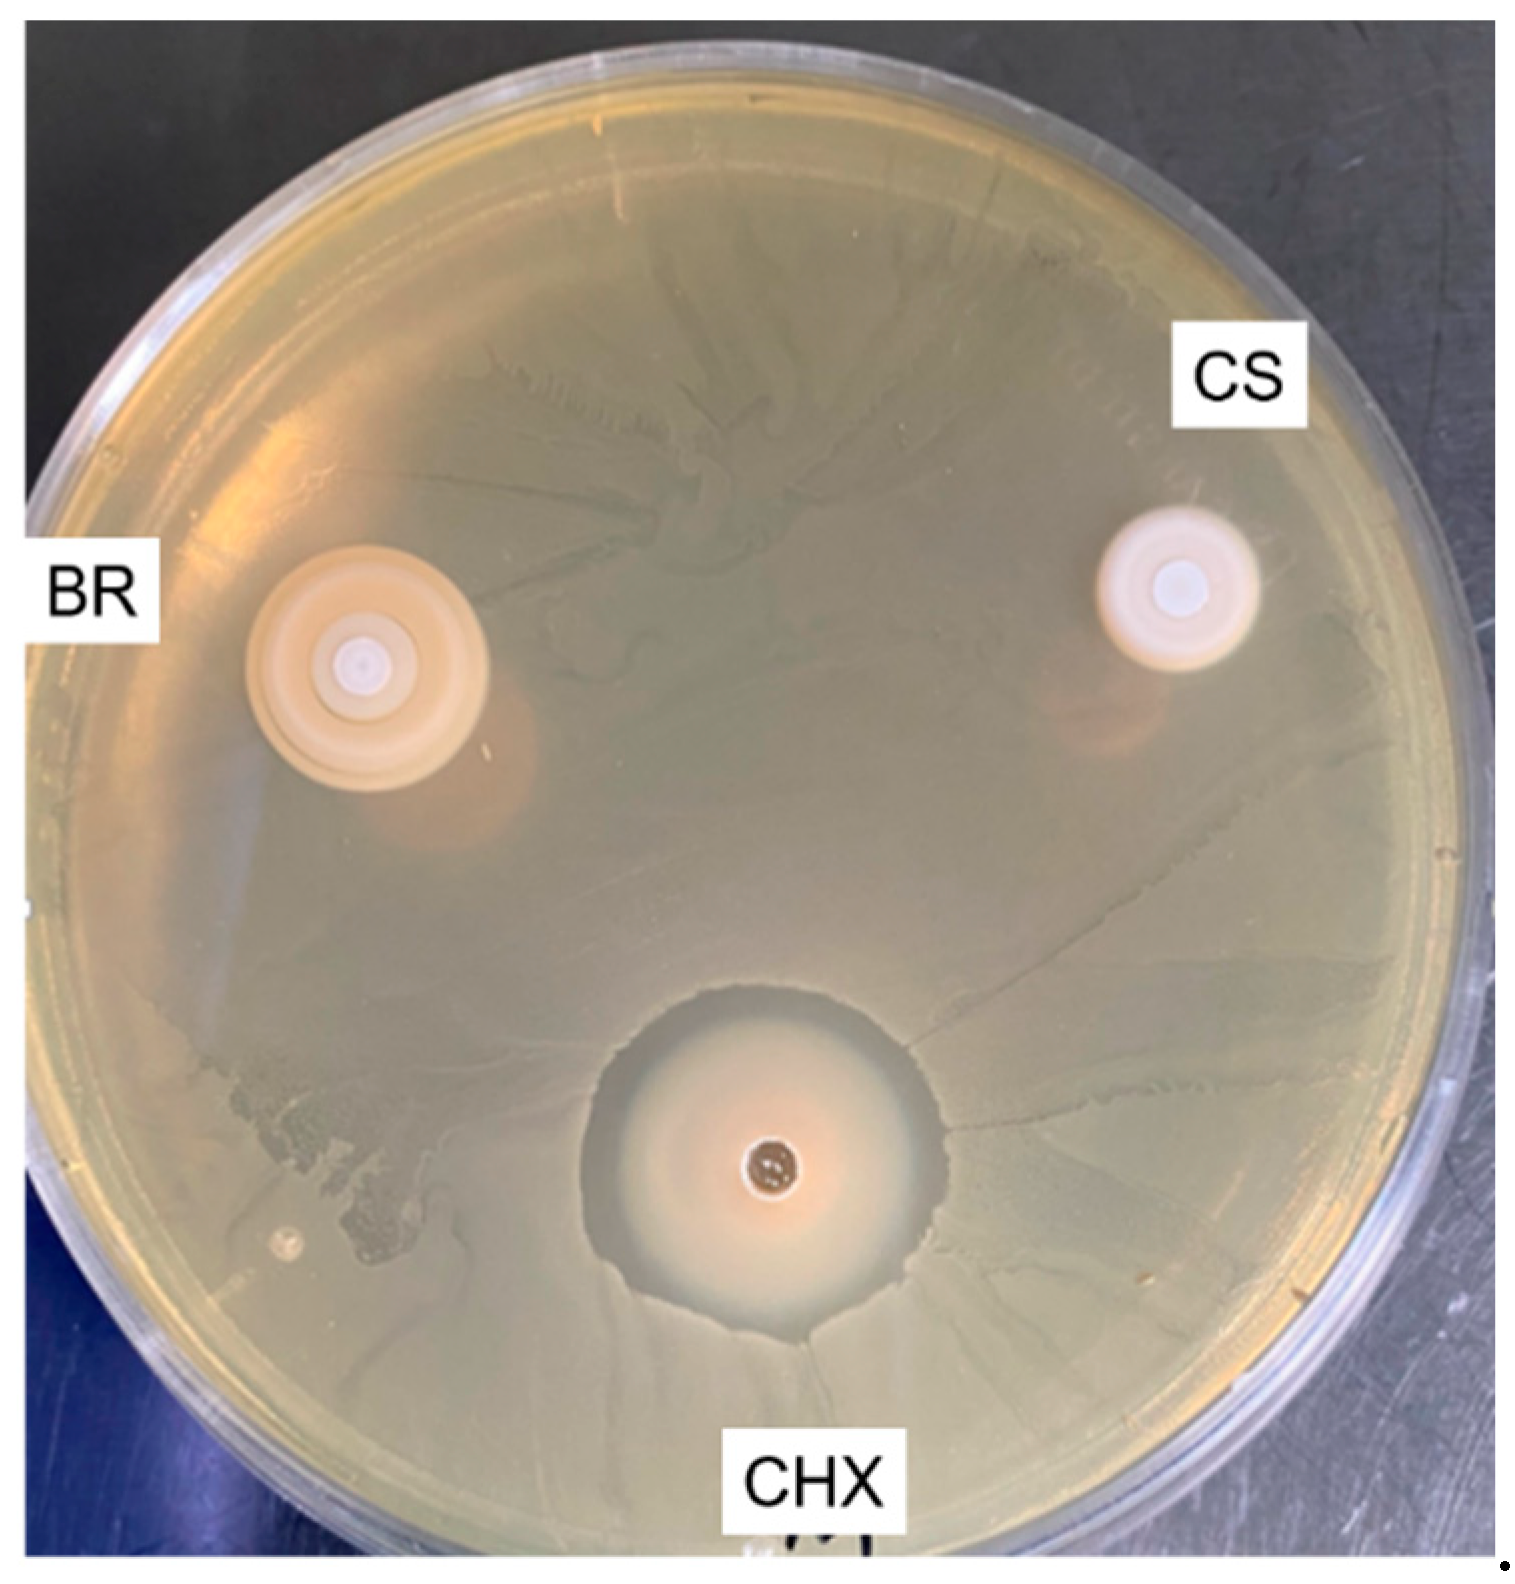
Jcm 09 03096 g007 Jcm 09 03096 g007

Physicochemical and Antibacterial Properties of Novel, Premixed Calcium Silicate-Based Sealer Compared to Powder–Liquid Bioceramic Sealer
Abstract
1. Introduction
2. Experimental Section
2.1. Filling Ability
- -
- Single-cone technique (SC1) with Ceraseal (Meta Biomed Co., Cheongju, Korea)
- -
- Single-cone technique (SC2) with BioRoot (Septodont, Saint Maur des Fossés, France)
2.2. pH Measurements of the Water in Contact with the Sealers
2.3. Solubility and Flow Tests
2.4. Scanning Electron Microscope (SEM) and Energy-Dispersive X-ray (EDX) Analysis
2.5. Surface Roughness and Water Sorption Tests
2.6. Compression Tests
2.7. Antibacterial Activity
2.7.1. Agar Test
2.7.2. Direct Test
2.8. Statistical Analysis
3. Results
3.1. Filling Ability at 2, 5, and 8 mm from the Apex
3.2. pH Measurements of the Water in Contact with the Sealers
3.3. Solubility and Flow Tests
3.4. Scanning Electron Microscope (SEM) and Energy-Dispersive X-ray (EDX) Analysis
3.5. Surface Roughness and Water Sorption Tests
3.6. Compression Tests
3.7. Antibacterial Activity
3.7.1. Agar Diffusion Test (ADT)
3.7.2. Direct Test
4. Discussion
5. Conclusions
Author Contributions
Funding
Conflicts of Interest
References
- Haapasalo, M.; Endal, U.; Zandi, H.; Coil, J.M. Eradication of endodontic infection by instrumentation and irrigation solutions. Endod. Top. 2005, 10, 77–102. [Google Scholar] [CrossRef]
- Park, E.; Shen, Y.; Haapasalo, M. Irrigation of the apical root canal. Endod. Top. 2012, 27, 54–73. [Google Scholar] [CrossRef]
- Sundqvist, G.; Figdor, D.; Persson, S.; Sjögren, U. Microbiologic analysis of teeth with failed endodontic treatment and the outcome of conservative re-treatment. Oral Surg. Oral Med. Oral Pathol. Oral Radiol. Endod. 1998, 85, 86–93. [Google Scholar] [CrossRef]
- Keleş, A.; Alcin, H.; Kamalak, A.; Versiani, M.A. Micro-CT evaluation of root filling quality in oval-shaped canals. Int. Endod. J. 2014, 47, 1177–1184. [Google Scholar] [CrossRef] [PubMed]
- Mohammadi, Z.; Abbott, P.V. The properties and applications of chlorhexidine in endodontics. Int. Endod. J. 2009, 42, 288–302. [Google Scholar] [CrossRef]
- Lee, K.-W.; Williams, M.C.; Camps, J.J.; Pashley, D.H. Adhesion of endodontic sealers to dentin and gutta-percha. J. Endod. 2002, 28, 684–688. [Google Scholar] [CrossRef]
- Viapiana, R.; Flumignan, D.L.; Guerreiro-Tanomaru, J.M.; Camilleri, J.; Tanomaru-Filho, M. Physicochemical and mechanical properties of zirconium oxide and niobium oxide modified Portland cement-based experimental endodontic sealers. Int. Endod. J. 2014, 47, 437–448. [Google Scholar] [CrossRef]
- Tanomaru-Filho, M.; Torres, F.F.E.; Chávez-Andrade, G.M.; de Almeida, M.; Navarro, L.G.; Steier, L.; Guerreiro-Tanomaru, J.M. Physicochemical Properties and Volumetric Change of Silicone/Bioactive Glass and Calcium Silicate-based Endodontic Sealers. J. Endod. 2017, 43, 2097–2101. [Google Scholar] [CrossRef]
- Khalil, I.; Naaman, A.; Camilleri, J. Properties of Tricalcium Silicate Sealers. J. Endod. 2016, 42, 1529–1535. [Google Scholar] [CrossRef]
- Cintra, L.T.A.; Benetti, F.; de Azevedo Queiroz, Í.O.; Ferreira, L.L.; Massunari, L.; Bueno, C.R.E.; de Oliveira, S.H.P.; Gomes-Filho, J.E. Evaluation of the Cytotoxicity and Biocompatibility of New Resin Epoxy-based Endodontic Sealer Containing Calcium Hydroxide. J. Endod. 2017, 43, 2088–2092. [Google Scholar] [CrossRef]
- Camilleri, J. Characterization and hydration kinetics of tricalcium silicate cement for use as a dental biomaterial. Dent. Mater. 2011, 27, 836–844. [Google Scholar] [CrossRef] [PubMed]
- Silva Almeida, L.H.; Moraes, R.R.; Morgental, R.D.; Pappen, F.G. Are Premixed Calcium Silicate-based Endodontic Sealers Comparable to Conventional Materials? A Systematic Review of In Vitro Studies. J. Endod. 2017, 43, 527–535. [Google Scholar] [CrossRef] [PubMed]
- López-García, S.; Myong-Hyun, B.; Lozano, A.; García-Bernal, D.; Forner, L.; Llena, C.; Guerrero-Gironés, J.; Murcia, L.; Rodríguez-Lozano, F.J. Cytocompatibility, bioactivity potential, and ion release of three premixed calcium silicate-based sealers. Clin. Oral Investig. 2020, 24, 1749–1759. [Google Scholar] [CrossRef] [PubMed]
- Kharouf, N.; Hemmerlé, J.; Haikel, Y.; Mancino, D. Technical Quality of Root Canal Filling in Preclinical Training at Strasbourg University Using Two Teaching Protocols. Eur. J. Dent. 2019, 13, 521–526. [Google Scholar] [CrossRef] [PubMed][Green Version]
- Debelian, G.; Trope, M. The use of premixed bioceramic materials in endodontics. G. Ital. Di Endod. 2016, 30, 70–80. [Google Scholar] [CrossRef]
- Cavenago, B.C.; Pereira, T.C.; Duarte, M.A.H.; Ordinola-Zapata, R.; Marciano, M.A.; Bramante, C.M.; Bernardineli, N. Influence of powder-to-water ratio on radiopacity, setting time, pH, calcium ion release and a micro-CT volumetric solubility of white mineral trioxide aggregate. Int. Endod. J. 2014, 47, 120–126. [Google Scholar] [CrossRef]
- Duarte, M.A.H.; Marciano, M.A.; Vivan, R.R.; Tanomaru Filho, M.; Tanomaru, J.M.G.; Camilleri, J. Tricalcium silicate-based cements: Properties and modifications. Braz. Oral Res. 2018, 32, e70. [Google Scholar] [CrossRef]
- Siboni, F.; Taddei, P.; Zamparini, F.; Prati, C.; Gandolfi, M.G. Properties of BioRoot RCS, a tricalcium silicate endodontic sealer modified with povidone and polycarboxylate. Int. Endod. J. 2017, 50 (Suppl. 2), e120–e136. [Google Scholar] [CrossRef]
- Jeong, J.W.; DeGraft-Johnson, A.; Dorn, S.O.; Di Fiore, P.M. Dentinal Tubule Penetration of a Calcium Silicate-based Root Canal Sealer with Different Obturation Methods. J. Endod. 2017, 43, 633–637. [Google Scholar] [CrossRef]
- Moinzadeh, A.T.; Zerbst, W.; Boutsioukis, C.; Shemesh, H.; Zaslansky, P. Porosity distribution in root canals filled with gutta percha and calcium silicate cement. Dent. Mater. 2015, 31, 1100–1108. [Google Scholar] [CrossRef]
- Camilleri, J. Sealers and warm gutta-percha obturation techniques. J. Endod. 2015, 41, 72–78. [Google Scholar] [CrossRef] [PubMed]
- Poggio, C.; Trovati, F.; Ceci, M.; Colombo, M.; Pietrocola, G. Antibacterial activity of different root canal sealers against Enterococcus faecalis. J. Clin. Exp. Dent. 2017, 9, e743–e748. [Google Scholar] [CrossRef] [PubMed][Green Version]
- Schäfer, E.; Zandbiglari, T. Solubility of root-canal sealers in water and artificial saliva. Int. Endod. J. 2003, 36, 660–669. [Google Scholar] [CrossRef] [PubMed]
- Mancino, D.; Kharouf, N.; Hemmerlé, J.; Haïkel, Y. Microscopic and Chemical Assessments of the Filling Ability in Oval-Shaped Root Canals Using Two Different Carrier-Based Filling Techniques. Eur. J. Dent. 2019, 13, 166–171. [Google Scholar] [CrossRef]
- Wu, M.K.; Fan, B.; Wesselink, P.R. Diminished leakage along root canals filled with gutta-percha without sealer over time: A laboratory study. Int. Endod. J. 2000, 33, 121–125. [Google Scholar] [CrossRef]
- Schneider, S.W. A comparison of canal preparations in straight and curved root canals. Oral Surg. Oral Med. Oral Pathol. 1971, 32, 271–275. [Google Scholar] [CrossRef]
- Costa, A.R.; Garcia-Godoy, F.; Correr-Sobrinho, L.; Naves, L.Z.; Raposo, L.H.; Carvalho, F.G.; Sinhoreti, M.A.; Puppin-Rontani, R.M. Influence of Different Dentin Substrate (Caries-Affected, Caries-Infected, Sound) on Long-Term μTBS. Braz. Dent. J. 2017, 28, 16–23. [Google Scholar] [CrossRef]
- de Souza, L.C.; Yadlapati, M.; Dorn, S.O.; Silva, R.; Letra, A. Analysis of radiopacity, pH and cytotoxicity of a new bioceramic material. J. Appl. Oral Sci. 2015, 23, 383–389. [Google Scholar] [CrossRef]
- Bernardi, A.; Bortoluzzi, E.A.; Felippe, W.T.; Felippe, M.C.S.; Wan, W.S.; Teixeira, C.S. Effects of the addition of nanoparticulate calcium carbonate on setting time, dimensional change, compressive strength, solubility and pH of MTA. Int. Endod. J. 2017, 50, 97–105. [Google Scholar] [CrossRef]
- Candeiro, G.T.M.; Moura-Netto, C.; D’Almeida-Couto, R.S.; Azambuja-Júnior, N.; Marques, M.M.; Cai, S.; Gavini, G. Cytotoxicity, genotoxicity and antibacterial effectiveness of a bioceramic endodontic sealer. Int. Endod. J. 2016, 49, 858–864. [Google Scholar] [CrossRef]
- Ree, M.; Schwartz, R. Clinical applications of premixed bioceramic materials in endodontics. ENDO 2015, 9, 111–127. [Google Scholar]
- Bortoluzzi, E.A.; Cassel de Araújo, T.; Carolina Corrêa Néis, A.; Cássia Dos Santos, M.; da Fonseca Roberti Garcia, L.; Dulcinéia Mendes Souza, B.; da Silveira Teixeira, C. Effect of different water-to-powder ratios on the dimensional stability and compressive strength of mineral aggregate-based cements. Eur. Oral Res. 2019, 53, 94–98. [Google Scholar] [CrossRef] [PubMed]
- Duque, J.A.; Fernandes, S.L.; Bubola, J.P.; Duarte, M.A.H.; Camilleri, J.; Marciano, M.A. The effect of mixing method on tricalcium silicate-based cement. Int. Endod. J. 2018, 51, 69–78. [Google Scholar] [CrossRef]
- Reyhani, M.-F.; Ghasemi, N.; Zand, V.; Mosavizadeh, S. Effects of Different Powder to liquid Ratios on the Push out Bond Strength of CEM Cement on Simulated Perforations in the Furcal Area. J. Clin. Exp. Dent. 2017, 9, e785–e788. [Google Scholar] [CrossRef] [PubMed]
- Al-Hiyasat, A.S.; Alfirjani, S.A. The effect of obturation techniques on the push-out bond strength of a premixed bioceramic root canal sealer. J. Dent. 2019, 89, 103169. [Google Scholar] [CrossRef]
- Viapiana, R.; Moinzadeh, A.T.; Camilleri, L.; Wesselink, P.R.; Tanomaru Filho, M.; Camilleri, J. Porosity and sealing ability of root fillings with gutta-percha and BioRoot RCS or AH Plus sealers. Evaluation by three ex vivo methods. Int. Endod. J. 2016, 49, 774–782. [Google Scholar] [CrossRef]
- Drukteinis, S.; Peciuliene, V.; Shemesh, H.; Tusas, P.; Bendinskaite, R. Porosity Distribution in Apically Perforated Curved Root Canals Filled with Two Different Calcium Silicate Based Materials and Techniques: A Micro-Computed Tomography Study. Materials 2019, 12, 1729. [Google Scholar] [CrossRef]
- Sritharan, A. Discuss that the coronal seal is more important than the apical seal for endodontic success. Aust. Endod. J. 2002, 28, 112–115. [Google Scholar] [CrossRef]
- Torabinejad, M.; Ung, B.; Kettering, J.D. In vitro bacterial penetration of coronally unsealed endodontically treated teeth. J. Endod. 1990, 16, 566–569. [Google Scholar] [CrossRef]
- Reyes-Carmona, J.F.; Felippe, M.S.; Felippe, W.T. A phosphate-buffered saline intracanal dressing improves the biomineralization ability of mineral trioxide aggregate apical plugs. J. Endod. 2010, 36, 1648–1652. [Google Scholar] [CrossRef]
- Abedi-Amin, A.; Luzi, A.; Giovarruscio, M.; Paolone, G.; Darvizeh, A.; Agulló, V.V.; Sauro, S. Innovative root-end filling materials based on calcium-silicates and calcium-phosphates. J. Mater. Sci. Mater. Med. 2017, 28, 31. [Google Scholar] [CrossRef] [PubMed]
- Kim, J.R.; Nosrat, A.; Fouad, A.F. Interfacial characteristics of Biodentine and MTA with dentine in simulated body fluid. J. Dent. 2015, 43, 241–247. [Google Scholar] [CrossRef] [PubMed]
- McMichael, G.E.; Primus, C.M.; Opperman, L.A. Dentinal Tubule Penetration of Tricalcium Silicate Sealers. J. Endod. 2016, 42, 632–636. [Google Scholar] [CrossRef] [PubMed]
- Rechenberg, D.-K.; Thurnheer, T.; Zehnder, M. Potential systematic error in laboratory experiments on microbial leakage through filled root canals: An experimental study. Int. Endod. J. 2011, 44, 827–835. [Google Scholar] [CrossRef] [PubMed]
- Tonini, R.; Giovarruscio, M.; Gorni, F.; Ionescu, A.; Brambilla, E.; Mikhailovna, I.M.; Luzi, A.; Maciel Pires, P.; Sauro, S. In Vitro Evaluation of Antibacterial Properties and Smear Layer Removal/Sealer Penetration of a Novel Silver-Citrate Root Canal Irrigant. Materials 2020, 13, 194. [Google Scholar] [CrossRef]
- Urban, K.; Neuhaus, J.; Donnermeyer, D.; Schäfer, E.; Dammaschke, T. Solubility and pH Value of 3 Different Root Canal Sealers: A Long-term Investigation. J. Endod. 2018, 44, 1736–1740. [Google Scholar] [CrossRef]
- Poggio, C.; Dagna, A.; Ceci, M.; Meravini, M.-V.; Colombo, M.; Pietrocola, G. Solubility and pH of bioceramic root canal sealers: A comparative study. J. Clin. Exp. Dent. 2017, 9, e1189–e1194. [Google Scholar] [CrossRef]
- Schwendicke, F.; Al-Abdi, A.; Pascual Moscardó, A.; Ferrando Cascales, A.; Sauro, S. Remineralization effects of conventional and experimental ion-releasing materials in chemically or bacterially-induced dentin caries lesions. Dent. Mater. 2019, 35, 772–779. [Google Scholar] [CrossRef]
- Elyassi, Y.; Moinzadeh, A.T.; Kleverlaan, C.J. Characterization of Leachates from 6 Root Canal Sealers. J. Endod. 2019, 45, 623–627. [Google Scholar] [CrossRef]
- Colombo, M.; Poggio, C.; Dagna, A.; Meravini, M.-V.; Riva, P.; Trovati, F.; Pietrocola, G. Biological and physico-chemical properties of new root canal sealers. J. Clin. Exp. Dent. 2018, 10, e120–e126. [Google Scholar] [CrossRef]
- Ball, V. Self-Assembly Processes at Interfaces, 1st ed.; Akademic Press: London, UK, 2018; pp. 1–241. [Google Scholar]
- Kontakiotis, E.G.; Tzanetakis, G.N.; Loizides, A.L. A comparative study of contact angles of four different root canal sealers. J. Endod. 2007, 33, 299–302. [Google Scholar] [CrossRef] [PubMed]
- Voicu, G.; Didilescu, A.C.; Stoian, A.B.; Dumitriu, C.; Greabu, M.; Andrei, M. Mineralogical and Microstructural Characteristics of Two Dental Pulp Capping Materials. Materials 2019, 12, 1772. [Google Scholar] [CrossRef] [PubMed]
- Yassen, G.H.; Sabrah, A.H.A.; Eckert, G.J.; Platt, J.A. Effect of different endodontic regeneration protocols on wettability, roughness, and chemical composition of surface dentin. J. Endod. 2015, 41, 956–960. [Google Scholar] [CrossRef] [PubMed]
- Gjorgievska, E.S.; Nicholson, J.W.; Coleman, N.J.; Booth, S.; Dimkov, A.; Hurt, A. Component Release and Mechanical Properties of Endodontic Sealers following Incorporation of Antimicrobial Agents. Biomed. Res. Int. 2017, 2017, 2129807. [Google Scholar] [CrossRef] [PubMed]
- Branstetter, J.; von Fraunhofer, J.A. The physical properties and sealing action of endodontic sealer cements: A review of the literature. J. Endod. 1982, 8, 312–316. [Google Scholar] [CrossRef]
- Moinzadeh, A.T.; Aznar Portoles, C.; Schembri Wismayer, P.; Camilleri, J. Bioactivity Potential of EndoSequence BC RRM Putty. J. Endod. 2016, 42, 615–621. [Google Scholar] [CrossRef]
- Alsubait, S.; Albader, S.; Alajlan, N.; Alkhunaini, N.; Niazy, A.; Almahdy, A. Comparison of the antibacterial activity of calcium silicate- and epoxy resin-based endodontic sealers against Enterococcus faecalis biofilms: A confocal laser-scanning microscopy analysis. Odontology 2019, 107, 513–520. [Google Scholar] [CrossRef]
- Chang, S.-W.; Lee, S.-Y.; Kang, S.-K.; Kum, K.-Y.; Kim, E.-C. In vitro biocompatibility, inflammatory response, and osteogenic potential of 4 root canal sealers: Sealapex, Sankin apatite root sealer, MTA Fillapex, and iRoot SP root canal sealer. J. Endod. 2014, 40, 1642–1648. [Google Scholar] [CrossRef]
- Portela, C.A.; Smart, K.F.; Tumanov, S.; Cook, G.M.; Villas-Bôas, S.G. Global metabolic response of Enterococcus faecalis to oxygen. J. Bacteriol. 2014, 196, 2012–2022. [Google Scholar] [CrossRef]
- Stuart, C.H.; Schwartz, S.A.; Beeson, T.J.; Owatz, C.B. Enterococcus faecalis: Its role in root canal treatment failure and current concepts in retreatment. J. Endod. 2006, 32, 93–98. [Google Scholar] [CrossRef]
- Huang, T.-H.; Chen, C.-L.; Hung, C.-J.; Kao, C.-T. Comparison of antibacterial activities of root-end filling materials by an agar diffusion assay and Alamar blue assay. J. Dent. Sci. 2012, 7, 336–341. [Google Scholar] [CrossRef]

| Materials | Manufacturer | Composition | Mixing |
|---|---|---|---|
| Ceraseal (CS) | Meta Biomed Co., Cheongju, Korea | Calcium silicates, zirconium oxide, thickening agent | Premixed (auto-mixing tip) |
| BioRoot RCS (BR) | Septodont, Saint Maur des Fossés, France | Powder: tricalcium silicate, zirconium oxide, and excipients. Aqueous solution: calcium chloride and excipients | Powder (1 scoop) and liquid (5 drops) |
| Levels | Groups | GPFA (%) | Sealer Area (%) | Voids (%) | |
|---|---|---|---|---|---|
| Interfacial | Intracanal | ||||
| 2 mm | CS | 71.88 ± 4.42 | 28.01 ± 4.37 | 0.11 ± 0.19 | 0 |
| BR | 67.86 ± 4.30 | 31.29 ± 4.36 | 0.85 ± 0.84 | 0 | |
| 5 mm | CS | 60.72 ± 6.71 | 39.12 ± 6.84 | 0.16 ± 0.36 | 0 |
| BR | 60.47 ± 6.52 | 39.28 ± 6.36 | 0.13 ± 0.25 | 0.12 ± 0.32 | |
| 8 mm | CS | 51.28 ± 2.02 | 48.72 ± 2.02 | 0 | 0 |
| BR | 51.70 ± 3.97 | 46.87 ± 4.12 | 0.31 ± 0.69 | 1.12 ± 1.54 | |
| Solubility | |||
|---|---|---|---|
| Group\Time | 1 Day | 7 Days | 14 Days |
| Ceraseal (%) | 10.72 ± 2.03 | 12.61 ± 0.44 | 13.92 ± 0.66 |
| BioRoot (%) | 12.71 ± 1.76 | 14.61 ± 0.64 | 16.51 ± 0.67 |
| Flow | |||
| Ceraseal (mm) | 27 ± 0.4 | ||
| BioRoot (mm) | 18 ± 0.3 | ||
| Sealer | Element (%) | 24 h | 72 h | 7 d (Water) | 14 d (Water) |
|---|---|---|---|---|---|
| BR | Ca | 35.69 ± 6.27 | 40.94 ± 9.76 | 43.35 ± 9.73 | 51.36 ± 4.57 |
| Zr | 6.25 ± 2.24 | 8.81 ± 1.78 | 1.71 ± 0.30 | 4.32 ± 1.93 | |
| Si | 1.89 ± 2.04 | 1.95 ± 1.20 | 0.77 ± 0.65 | 0.69 ± 0.42 | |
| Cl | 11.75 ± 2.44 | 3.63 ± 0.47 | 0.31 ± 0.09 | 0.58 ± 0.51 | |
| CS | Ca | 24.56 ± 12.23 | 39.59 ± 6.17 | 29.56 ± 10.43 | 44.10 ± 4.52 |
| Zr | 1.04 ± 0.68 | 4.66 ± 2.88 | 24.08 ± 13.11 | 5.98 ± 2.86 | |
| Si | 0.41 ± 0.14 | 0.85 ± 0.55 | 1.24 ± 0.91 | 0.60 ± 0.17 |
| BioRoot | Ceraseal | p Values | |
|---|---|---|---|
| Absorption time (min) | 15 ± 1 | 18 ± 1.4 | 0.002 |
| Contact angle (ϴ°) | 34.76 ± 1.26 | 42.38 ± 0.91 | ≤0.001 |
| Surface roughness (Ra, nm) | 67.81 ± 21.32 | 22.83 ± 3.92 | 0.008 |
© 2020 by the authors. Licensee MDPI, Basel, Switzerland. This article is an open access article distributed under the terms and conditions of the Creative Commons Attribution (CC BY) license (http://creativecommons.org/licenses/by/4.0/).
Share and Cite
Kharouf, N.; Arntz, Y.; Eid, A.; Zghal, J.; Sauro, S.; Haikel, Y.; Mancino, D. Physicochemical and Antibacterial Properties of Novel, Premixed Calcium Silicate-Based Sealer Compared to Powder–Liquid Bioceramic Sealer. J. Clin. Med. 2020, 9, 3096. https://doi.org/10.3390/jcm9103096
Kharouf N, Arntz Y, Eid A, Zghal J, Sauro S, Haikel Y, Mancino D. Physicochemical and Antibacterial Properties of Novel, Premixed Calcium Silicate-Based Sealer Compared to Powder–Liquid Bioceramic Sealer. Journal of Clinical Medicine. 2020; 9(10):3096. https://doi.org/10.3390/jcm9103096
Chicago/Turabian StyleKharouf, Naji, Youri Arntz, Ammar Eid, Jihed Zghal, Salvatore Sauro, Youssef Haikel, and Davide Mancino. 2020. "Physicochemical and Antibacterial Properties of Novel, Premixed Calcium Silicate-Based Sealer Compared to Powder–Liquid Bioceramic Sealer" Journal of Clinical Medicine 9, no. 10: 3096. https://doi.org/10.3390/jcm9103096
APA StyleKharouf, N., Arntz, Y., Eid, A., Zghal, J., Sauro, S., Haikel, Y., & Mancino, D. (2020). Physicochemical and Antibacterial Properties of Novel, Premixed Calcium Silicate-Based Sealer Compared to Powder–Liquid Bioceramic Sealer. Journal of Clinical Medicine, 9(10), 3096. https://doi.org/10.3390/jcm9103096

